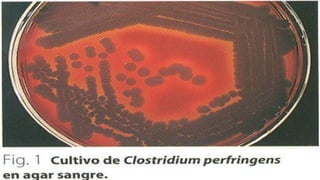

El documento aborda la clasificación y características del género Clostridium, destacando su naturaleza anaerobia, formación de esporas y toxinas. Se mencionan las infecciones asociadas, como el tétano y el botulismo, así como sus manifestaciones clínicas y medidas de tratamiento. Además, se señala la prevalencia del Clostridium en ambientes como suelos y tractos gastrointestinales de mamíferos, y la resistencia de sus esporas a condiciones adversas.